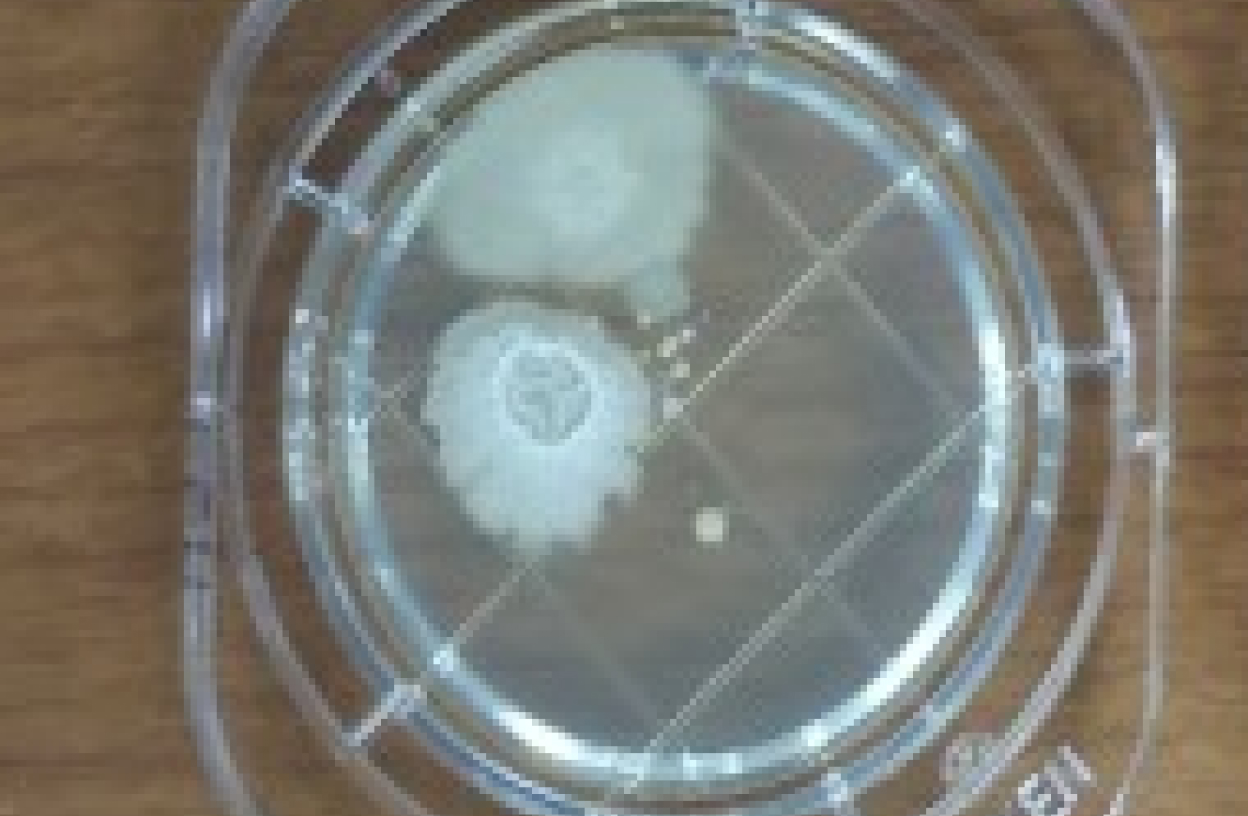
水道水で洗浄したモップ スタンプ検査

E
Environment
環境
S
Sanitation
衛生
M
Management
管理
触媒水
人と環境に優しい次世代の
清掃システム
ESM触媒水は、OHラジカルの力を活かして生成される、環境にやさしい機能水です。
洗剤に頼らず、除菌・消臭・洗浄を可能にし、人・施設・環境すべてに配慮した新しい清掃・衛生管理を実現します。

ESM触媒水が解決する
清掃業務の悩み
-
除菌 が徹底できない
衛生管理が厳しい現場で、確実な除菌が求められるが
効果が不安。 -
臭い が消えない
ゴミ箱周辺、排水口の臭いが消えない。
消臭剤では一時的な効果しかない。 -
洗浄力 が足りない
すすぎ不要、毎日の洗浄で汚れ落ちを実感。
排水するだけで配管内の汚れやバイオフィルムを分解。 -
作業時間 がかかる
複数の洗剤を使い分け、すすぎに時間がかかる。
作業効率が上がらない。 -
資材費・人件費 を減らしたい
洗剤・水道代が高い。
作業量が多く、人件費がかかる。 -
安全性・規制 への対応
強力な薬剤は取り扱いに不安がある。
環境規制やオゾン規制への対応が必要。
ESM触媒水は、OHラジカルの力で安全かつ経済的に課題を解決します。
薬品を使わない安全な洗浄水
水道ホースに取り付けるだけで、
特殊セラミックと専用薬剤で水道水から水素だけを取り除いた「高い酸化作用を有する触媒水」を生成します。
有機汚染物質と化学反応を起こしやすい性質を持ち、
汚れや臭い、ウイルスを分解除去いたします。

ESM触媒水
の3つの特徴
-
POINT01塩素の約2倍の酸化力で圧倒的な除菌力・消臭力・洗浄力
OHラジカルが汚れ、細菌やウイルスの臭いの原因物質の分子構造を瞬時に破壊し、根本から分解します。
洗剤と違って残留物がないため、汚れが再付着しにくく清潔が長続きします。 -
POINT02反応後は水に戻るから人にも環境にも優しい安全性
反応後は水に戻るだけなので、人やペットに無害です。
化学薬品不使用で、肌や環境にも優しく安心して使えます。
また、設備、素材を傷めないため使用場所を問いません。 -
POINT03水道代も作業時間もダウンコストダウンと作業効率の向上
電源不要で水道に繋ぐだけの小型装置で、洗剤・水道代・人件費に直結する大幅なコスト削減を実現します。
泡が出ないため「すすぎ」や洗剤管理が不要。作業工程そのものを減らし、誰でも簡単に清掃時間を短縮できます。
OHラジカルが有機物を分解
安全で強力な洗浄力の仕組み

ESM触媒水発生装置により 生成されたOHラジカル

OHラジカルが有機物(汚れ、雑菌、臭いの原因菌など)
から水素(H)を奪い取ることで、
酸化作用により汚れの分子構造を破壊

水素(H)を奪い取ったOHラジカルは 水分子(H2O)になるため残留物なし
触媒水がつくられる時に、水(H₂O)の中に「OHラジカル」と呼ばれる特別な分子が生まれます。
このOHラジカルは、水から水素(H)を1つだけ取った形で、非常に不安定な状態にあります。
そのため、元の安定した水に戻ろうとして、まわりの汚れや菌と強く反応します。このときに起こるのが「酸化作用」です。
OHラジカルが汚れや菌から水素(H)を奪い取り、汚れや菌は分解されます。
そして、OHラジカル自身はその水素と結びついてふたたび水(H₂O)に戻ります。

ESM触媒水装置は
電気分解を使わない
「触媒生成」で、
特許取得した製品です。
- 特許番号
- 特許第7376196号
- 発明の名称
- 清掃用液体生成装置
- 特許権者
- 株式会社ESサービス
- 登録日
- 令和5年(2023年)10月30日

ESM触媒水の性能
OHラジカルが塩素の約2倍の酸化力で汚れ、細菌やウイルスの臭いの原因物質の分子構造を瞬時に破壊し、根本から分解します。
スーパー店舗売場内床面油汚れ

厨房からの持ち込みによる油汚れ

ESM触媒水をスプレーボトルに入れ
毎日噴霧しモップで拭き上げ
靴に付着した厨房の油汚れがフロアーへ運ばれ汚れていることが気になっていましたが、
触媒水を使用することにより綺麗になりました。
飲食店厨房設備の除菌

測定値30096RLU

測定値77RLU
キッコーマンのルミテスタースマートを使用し、ESM触媒水の除菌効果を測定いたしました。(500 RLU以下を「良好」)
ESM触媒水と清掃用洗剤・薬剤との性能比較表
| ESM触媒水 | 中性洗剤 | アルカリ性洗剤 酸性洗剤 | 塩素系洗剤 | アルコール系除菌剤 | |
|---|---|---|---|---|---|
| 主成分 | OHラジカル(中性) | 界面活性剤 増粘剤 |
アルカリ:水酸化ナトリウム 酸性:塩酸・クエン酸等 |
次亜塩素酸ナトリウム | エタノール or イソプロパノール |
| 洗浄力 | |||||
| 除菌力 | |||||
| 消臭効果 | |||||
| 刺激性 | |||||
| 即効性 | |||||
| 持続性 | |||||
| 安全性 | |||||
| 残留物 | |||||
| コスト | |||||
| 環境負荷 |
他の洗浄水と性能比較表
| ESM触媒水 | オゾン水 | アルカリ電解水 | ナノバブル水 | |
|---|---|---|---|---|
| 主成分 | OHラジカル(中性) | 溶解オゾン | 高pH水 | 微細気泡入り水 |
| 洗浄力 | ||||
| 除菌力 | ||||
| 消臭効果 | ||||
| 刺激性 | ||||
| 即効性 | ||||
| 持続性 | ||||
| 安全性 | ||||
| 残留物 | ||||
| コスト | ||||
| 環境負荷 | ||||
| オゾン規制 |
その他性能試験データ
ATPふき取り検査(A3法)
による試験結果
| 洗浄前 | 洗浄後(直後) | |
|---|---|---|
| ESM触媒水でのおもちゃ洗浄 ATP基準:500以下が清潔基準値 | 999,999RLU | 294RLU |
| 手洗い前 | 手洗い後(直後) | |
|---|---|---|
| ESM触媒水での手指消毒 ATP基準:500以下が清潔基準値 | 36,663RLU | 1,260RLU |
| アルコールでの手指消毒 | 20,999RLU | 10,512RLU |
アルカリ電解水とESM触媒水の
不純物調査
粉塵、水質検査顕微鏡で測定

①アルカリ電解水
不純物が多くみられます(炭酸カリウム)
使用時、すすぎ作業をしないと、不純物が汚れを呼び再汚染原因になります

②ESM触媒水
ほとんど残留物がなく、水道水とほぼ同等の残留物(水分のゴミ、ミネラル分)のため、使用後の再汚染が見られません。

③水道水
残留物はゴミとミネラル分です。
アルカリ電解水は、被電解物質が不純物として残るため、従来の界面活性剤程ではないが対象物の表面に付着し、汚れを引き寄せる(再汚染)ことになるため、すすぎ作業は必要になります。一方、ESM触媒水は水道水同等の不純物のため再汚染の心配がほとんどありません。
スタンプ法による
ESM触媒水の除菌効果
ESM触媒水をハンドスプレー器に入れ
指に吹きかけ除菌
除菌前の指と除菌後の指を元にスタンプ検査を行い24時間後の一般細菌増殖結果
除菌前
指の触れた部分に大量な菌が増殖しています。

ESM触媒水による除菌後
全く菌が増殖していません。
ESM触媒水の活用シーン
ESM触媒水だけで洗浄・除菌・消臭。
あらゆる現場に対応。
人にも素材にもやさしい安全な水の力で、
幅広い業種でご活用いただけます。
-

日常清掃
界面活性剤を使わないため、清掃後の水拭きや薬剤残りの心配がありません。テーブルやスイッチ類などのウイルス・細菌を瞬時に除去。サッと拭くだけで、清掃時間の短縮と衛生レベルの向上を両立します。
-

定期清掃
従来の洗剤を使用した床・硝子清掃に比べ、未発泡の触媒水の活用により作業効率の向上が期待できます。また、水へ戻る特性により残留物がなく、汚れの再付着抑制にも寄与します。洗浄・除菌・消臭の機能を併せ持つことで、定期清掃の品質向上と衛生環境の底上げに寄与します。
-

食品工場・厨房
食材に触れても安心なため、まな板をはじめとした調理器具の除菌に最適。さらにグリストラップの油脂や汚泥も強力に分解し、悪臭・配管詰まりを解消。清掃コストの大幅な削減に貢献します。
-

畜産・ペット関連施設
ペットショップや動物病院、畜産現場にとって重要な「ニオイ対策」と「感染症対策」。塩素臭などの刺激臭がないため、嗅覚の鋭い動物たちにストレスを与えません。万が一舐めても無害な安全性と、頑固なアンモニア臭やウイルスを強力分解するパワーを兼ね備えています。
-

ゴミ置き場
ゴミ置き場特有の強烈な腐敗臭や生ゴミ臭。OHラジカルはニオイをごまかすのではなく、悪臭の原因物質を分子レベルで破壊します。ハエなどの害虫が寄り付きにくい環境を作ります。
-

エアコン内部洗浄
エアコン内部のアルミフィンやフィルターに付着したカビや雑菌を、OHラジカルが根こそぎ分解・除去します。強力なアルカリ洗剤とは異なり、金属を腐食させにくく、洗浄後のすすぎ作業も軽減。吹き出す風が、カビ臭さのない爽やかな空気に変わります。
-

冷却塔(クーリングタワー)
冷却塔トラブルの主原因であるぬめり・藻を強力に剥離・除去します。ぬめりの内部に潜むレジオネラ属菌の温床を破壊することで、繁殖リスクを激減。熱交換効率の低下を防ぎ、薬剤コストの削減と設備の延命に貢献します。
-

プール・温泉施設
従来の塩素消毒と異なり、OHラジカルにより菌が増えにくい環境を形成し、塩素臭のない快適な利用環境を提供します。「発生させない」予防的管理へと、レジオネラ菌対策を質的に進化させます。
様々な現場で活用いただけます
-

飲食店・厨房 -

食品加工場・製造施設 -

野菜農家・畜産業 -

オフィス・店舗・公共施設 -

介護・医療施設 -

宿泊施設(ホテル・旅館) -

ペット関連施設 -

スポーツ・フィットネス施設
ESM触媒水装置の使い方
電源不要で簡単に使用できます

-
01
取り付け
水道ホースに取り付け、装置の投入口にタブレットを入れてください。電源不要。これで準備完了です。
-
02
触媒水生成
普段通り蛇口から水を出してください。
発生装置を通すだけで触媒水が生成されます。 ※ボトルなどに移す場合は、時間が経つほど効果は弱くなっていきますので、基本的には1日ごとに詰め替えることをおすすめします。 -
03
清拭・噴霧・空間除菌
ホースから直接使用、ボトルに詰めて噴霧して使用。
ポリッシャー・お掃除ロボの洗浄液代わりに。
加湿器の水として場所を選ばず多様にご利用いただけます。
よくある質問
Q 生成した触媒水はどのくらい保存できますか?
ESM触媒水は生成時に発生するOHラジカルの活性を活かした機能水です。
OHラジカルは時間の経過とともに安定した水へと戻る性質があるため、長期保存には適していません。
効果を最大限に発揮させるため、生成後はできるだけ早く(当日中を目安に)ご使用いただくことを推奨しています。
Q 容器に移し替えた場合、効果は持続しますか?
移し替えての使用も可能ですが、活性成分であるOHラジカルは徐々に減少します。
本装置は「必要な分をその都度生成し、新鮮な状態で使用する」運用を想定した設計となっています。
ストック(溜め置き)しての保存ではなく、その日のうちに使い切る量を生成してご使用ください。
Q 油汚れにも効果がありますか?
はい、高い効果を発揮します。 ESM触媒水には油脂分を乳化・分解しやすくする作用があるため、厨房の床や換気扇、排水まわりのヌメリ除去に効果的です。
ただし、長期間放置され固着した重度の油汚れについては、初回清掃時に限り
従来の洗剤と併用することで、より効率的に汚れを落とすことができます。
Q 効果がない、または使用を避けるべき場所はありますか?
基本的には水拭き、水洗いが可能な場所であればどこでも使用可能ですが、以下の点にご注意ください。
重度の特殊汚染: 完全に硬化した汚れや、厚く蓄積した汚れの除去には専用薬剤が必要な場合があります。
デリケートな素材: 水に弱い素材に使用する場合は、事前に目立たない場所でテストすることをお勧めします。
Q 飲水として使用できますか?
本装置で生成された水は、「水道水質基準」に適合していることを確認済みですので、万が一、清掃中に口に入ったり肌に触れたりしても安全です。
ただし、本製品はあくまで洗浄・除菌・消臭を目的とした「機能水」であり、飲用を目的として
開発されたものではありませんので飲用はお控えください。
Q どのくらいの規模の施設から導入可能ですか?
装置本体はコンパクト設計のため、水道設備さえあれば規模を問わず導入いただけます。
使用量や設置環境に合わせて、最適な設置プランをご提案します。
Q トライアル(試験導入)はできますか?
はい、承っております。 まずは実際の現場で「汚れ落ちの良さ」や「作業のしやすさ」をご体感ください。
期間や対象範囲などの詳細については、担当者が個別にご相談に応じます。
Q 導入後のサポート体制はどうなっていますか?
お客様に安心して継続利用いただけるよう、万全の体制を整えています。
運用サポート: 効果的な使用方法や清掃オペレーションのご提案
メンテナンス: 機器トラブル時の迅速なメーカー対応
定期フォロー: 導入後の状況確認や改善提案
料金
まずは無料トライアルで性能をお確かめください
-
製品レンタル
- 月額料金(1年契約)
- 18,000円(税抜)
含まれるサービス
- ・1年間の保証
- ・内部洗浄
- ※上水使用の場合:2年に1回(無償)
- ※中水等使用の場合:1年に1回(無償)
- ・交換薬剤
- ご利用条件あり
-
製品購入
- 1台あたりの価格
- 定価
450,000
円(税抜)
- ※導入条件により最適なご提案が可能です。
まずはお気軽にお問い合わせください。 - ※導入条件により最適なご提案が可能です。
別途費用
-
・交換薬剤:6個入 2,400円(税抜)
- ※薬剤1個あたり、約1.5~2tの触媒水を生成可能
- ・内部洗浄:1回 40,000円(税抜)
- ※上水使用の場合:2年に1回推奨
- ※中水等使用の場合:1年に1回推奨
-
ソリューション
- お問い合わせ
ご提案いたします
- 冷却塔(クーリングタワー)、プール、温泉設備等、大型設備への導入をご検討の方はまずはご相談ください。お客様の設備に合わせた柔軟なソリューションをご提案いたします。
お電話からのお問い合わせ
03-5289-3936
9:00~17:30(土日・祝日・年末年始を除く)
トライアル申し込み
お問い合わせ
サービスについてのご相談・お見積り
お問い合わせはこちらから


